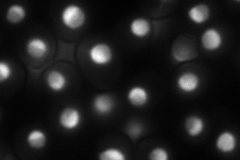
YNL110C
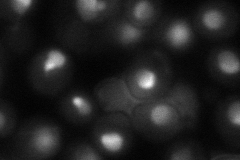
YNL110C
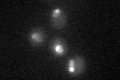
YNL110C

View description
Constituent of 66S pre-ribosomal particles, involved in 60S ribosomal subunit biogenesis; localizes to both nucleolus and cytoplasm
Localization:
Intensity:
Fold change:
Significance:
-
C’ GFP library in SD

nucleus113.38 -
N' NOP1pr-GFP in SD
nucleolus150.846 -
N' TEF2pr-mCherry in SD

nucleus,nucleolus210.618 -
N' NATIVEpr-GFP in SD

nucleus136.34 -
N' TEF2pr-VC and Cyto-VN in SD
nucleus,nucleolus61.4208 -
C’ GFP library in SD+DTT

nucleus71.540.63Yes -
C’ GFP library in SD+H2O2

nucleus45.490.4Yes -
C’ GFP library in Starvation Media
nucleus33.80.29Yes -
C’ GFP library on the background of Pup2-DaMP

N/A -
C’ GFP library on the background of CCT mutant

N/A0N/AYes
